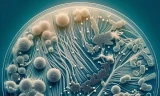
Nữ sinh tử vong do bạch hầu ở Nghệ An từng tiếp xúc hơn 100 người

TS. Đỗ Thiện Hải, Phó Giám đốc Trung tâm Bệnh Nhiệt đới trẻ em (Bệnh viện Nhi Trung ương) cho biết bệnh bạch hầu là bệnh nhiễm trùng cấp tính do vi khuẩn Corynebacterium diphtheriae gây ra, có đặc điểm lâm sàng là màng giả xuất hiện ở chỗ nhiễm trùng. Bất cứ đối tượng nào tiếp xúc với mầm bệnh đều có thể bị bệnh bạch hầu. Thông thường, trẻ từ 1 đến 10 tuổi bị nhiều nhất là do kháng thể từ người mẹ truyền sang không còn. Bệnh cũng có thể gặp ở người lớn nếu không có miễn dịch.
Đường lây truyền
Người là ổ chứa của vi khuẩn bạch hầu. Bệnh lây truyền chủ yếu qua tiếp xúc với người bệnh hoặc người lành mang trùng bởi các chất tiết đường hô hấp hoặc qua các chất dịch ở sang thương ngoài da có chứa vi khuẩn bạch hầu.
“Bệnh lây truyền dễ dàng qua đường hô hấp hoặc qua tiếp xúc trực tiếp với dịch tiết từ niêm mạc mũi họng của bệnh nhân hoặc người lành mang trùng khi ho, hắt hơi, đặc biệt trong khu vực dân cư đông đúc hoặc nơi có điều kiện vệ sinh không đảm bảo”, bác sĩ Hải thông tin.
Thời gian ủ bệnh thường từ 2 đến 5 ngày, có thể lâu hơn. Thời kì lây truyền bệnh thường không cố định, có thể kéo dài khoảng 2 tuần hoặc ngắn hơn, ít nhất là trên 4 tuần. Người bệnh đã có thể đào thải vi khuẩn từ thời kì khởi phát, hoặc cũng có thể từ cuối thời kì ủ bệnh. Người lành mang vi khuẩn bạch hầu có thể từ vài ngày đến 3- 4 tuần.
 |
Biểu hiện bệnh
Biểu hiện bệnh có thể từ nhẹ đến nặng, thường có giả mạc màu trắng ở tuyến hạnh nhân, hầu họng, thanh quản, mũi, có thể xuất hiện ở da, các màng niêm mạc khác như kết mạc mắt hoặc bộ phận sinh dục, trường hợp nặng có thể gây biến chứng và tử vong.
Bệnh bạch hầu mũi trước
Bệnh nhân sổ mũi, chảy ra chất mủ nhầy đôi khi có máu, có màng trắng ở vách ngăn mũi. Thể bệnh thường nhẹ do độc tố vi khuẩn ít thâm nhập vào máu.
Bệnh bạch hầu họng và amidan
Bệnh nhân mệt mỏi, đau cổ họng, chán ăn, sốt nhẹ. Sau 2, 3 ngày xuất hiện một đám hoại tử tạo thành lớp giả mạc màu trắng xanh, dai và dính chắc vào amiđan, hoặc có thể lan rộng bao phủ cả vùng hầu họng. Trong một số trường hợp, bệnh nhân có thể sưng nề vùng dưới hàm và sưng các hạch vùng cổ làm cổ bạnh ra như cổ bò. Những trường hợp nhiễm độc nặng bệnh nhân sẽ phờ phạc, xanh tái, mạch nhanh, đờ đẫn, hôn mê. Nếu không được điều trị tích cực, những bệnh nhân này có thể tử vong trong vòng 6 đến 10 ngày.
Bạch hầu thanh quản
Là thể bệnh tiến triển nhanh và nguy hiểm. Bệnh nhân có dấu hiệu sốt nhẹ, khàn tiếng, ho, các giả mạc tại thanh quản hoặc từ hầu họng lan xuống. Nếu không được điều trị kịp thời, các giả mạc có thể gây tắc đường thở, làm bệnh nhân suy hô hấp và tử vong nhanh chóng.
Ngoài những vị trí kể trên, vi khuẩn còn có thể gây bệnh ở một số vị trí khác nhưng những trường hợp này rất hiếm và có tiến triển bệnh nhẹ.
Biến chứng
Bác sĩ Lê Thị Phượng, Trung tâm tim mạch (Bệnh viện Nhi Trung ương) cho biết: “Những trường hợp bạch hầu nặng và tử vong thường liên quan đến tổn thương tim, hay gặp nhất là Viêm cơ tim, Rối loạn nhịp tim, có thể gặp Viêm nội tâm mạc, Viêm màng ngoài tim… Việc chẩn đoán sớm dựa vào theo dõi sát lâm sàng, điện tâm đồ liên tục, siêu âm tim, xét nghiệm marker tổn thương cơ tim,…giúp giảm tỉ lệ tử vong”.
 |
| Bạch hầu là bệnh truyền nhiễm nguy hiểm (ảnh minh họa: Nguyễn Thắng). |
Ngoài ra, bạch hầu có biến chứng thần kinh thường xuất hiện sau một thời gian muộn hơn. Liệt khẩu cái cả hai bên và thường liệt vận động, liệt phần mềm của lưỡi gà tuần thứ 3, liệt cơ vận nhãn thường xuất hiện tuần thứ 5, nhưng cũng có thể xuất hiện trong tuần đầu đó là nguyên nhân gây cho bệnh nhân nhìn mờ, và lác . Viêm dây thần kinh cơ hoành, gây liệt cơ hoành thường ở tuần thứ 5 đến tuần thứ 7. Liệt các chi hoàn toàn nhưng hiếm gặp. Hầu hết các biến chứng thần kinh sẽ phục hồi hoàn toàn trong nhiều tuần đến nhiều tháng.
Phòng bệnh
Trước đây, bệnh lưu hành khá phổ biến ở hầu hết các địa phương trên cả nước. Từ khi vắc xin phòng bạch hầu được đưa vào chương trình tiêm chủng mở rộng, bệnh đã được khống chế và chỉ ghi nhận một vài trường hợp lẻ tẻ do không tiêm vắc xin phòng bệnh, thường xảy ra ở các khu vực vùng sâu, vùng xa nơi có tỉ lệ tiêm chủng thấp.
Tuy nhiên những năm gần đây, bệnh bạch hầu liên tiếp xuất hiện nhiều tại những tỉnh ở miền Trung, Tây Nguyên như Quảng Nam, Quảng Ngãi, Đà Nẵng, Đắk Lắk… Từ rải rác xuất hiện một, hai trường hợp ở một số vùng, gần đây liên tiếp hàng chục bệnh nhân nhiễm bệnh được ghi nhận.
Cục Y tế Dự phòng (Bộ Y tế) cho biết hiện bệnh bạch hầu chưa được loại trừ ở nước ta. Do đó, người dân vẫn có thể mắc bệnh nếu chưa tiêm vắc xin phòng bệnh và tiếp xúc với mầm bệnh. Để chủ động phòng, chống bệnh bạch hầu, Cục Y tế dự phòng khuyến cáo người dân cần đưa trẻ đi tiêm chủng tiêm vắc xin phòng bệnh bạch hầu theo lịch tiêm chủng đầy đủ, đúng lịch; thường xuyên rửa tay bằng xà phòng; che miệng khi ho hoặc hắt hơi; giữ vệ sinh thân thể, mũi, họng hằng ngày; hạn chế tiếp xúc với người mắc bệnh hoặc nghi ngờ mắc bệnh; đảm bảo nhà ở, nhà trẻ, lớp học thông thoáng, sạch sẽ và có đủ ánh sáng.
Khi có dấu hiệu mắc bệnh hoặc nghi ngờ mắc bệnh bạch hầu, bệnh nhân phải được cách li và đưa đến cơ sở y tế để được khám, điều trị kịp thời. Người dân trong ổ dịch cần chấp hành nghiêm túc việc uống thuốc phòng, tiêm vắc xin phòng bệnh theo chỉ định và yêu cầu của cơ quan y tế.